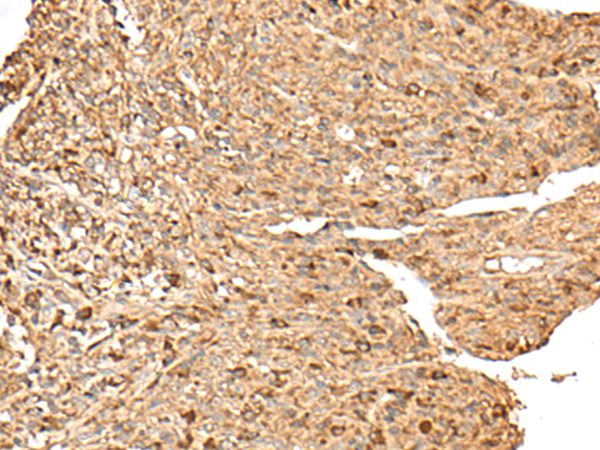

-
分类: 科研抗体货号: P02827别名: PRL3; PRL-3; PRL-R应用: WB反应种属: Human
-
分类: 科研抗体货号: P02784别名: GITA; ARMC13应用: IHC反应种属: Human
-
分类: 科研抗体货号: P02858别名: CDC8; TMPK; TYMK; PP3731应用: WB,IHC反应种属: Human, Mouse
-
分类: 科研抗体货号: P02824别名: ARK; hRNF111应用: WB,IHC反应种属: Human, Mouse
-
分类: 科研抗体货号: P02782别名: TRM1应用: WB,IHC反应种属: Human, Mouse
-
分类: 科研抗体货号: P02857别名: HC10-II应用: WB,IHC反应种属: Human, Mouse, Rat
-
分类: 科研抗体货号: P02823别名: L28应用: WB反应种属: Human, Mouse, Rat
-
分类: 科研抗体货号: P02781别名: ATAC2; CRP2BP; CSRP2BP; PRO1194; dJ717M23.1应用: IHC反应种属: Human, Mouse
-
分类: 科研抗体货号: P02856别名: RAB7L; RAB7L1应用: WB,IHC反应种属: Human, Mouse, Rat
-
分类: 科研抗体货号: P02820别名: S12应用: WB,IHC反应种属: Human, Mouse, Rat

鄂公网安备42018502007531号
鄂公网安备42018502007531号

